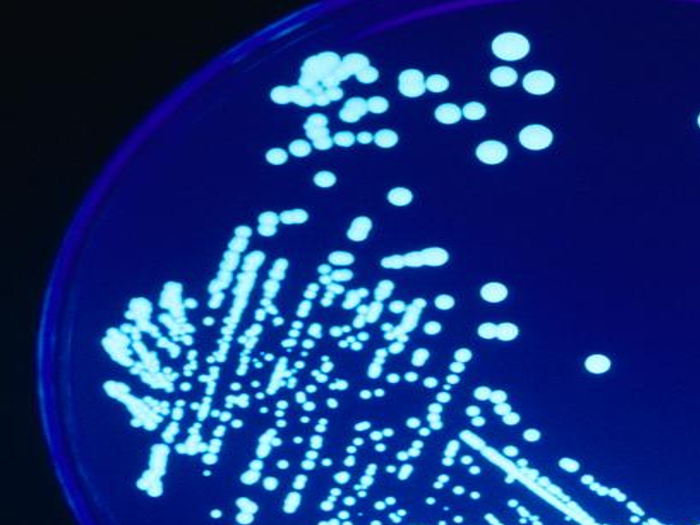
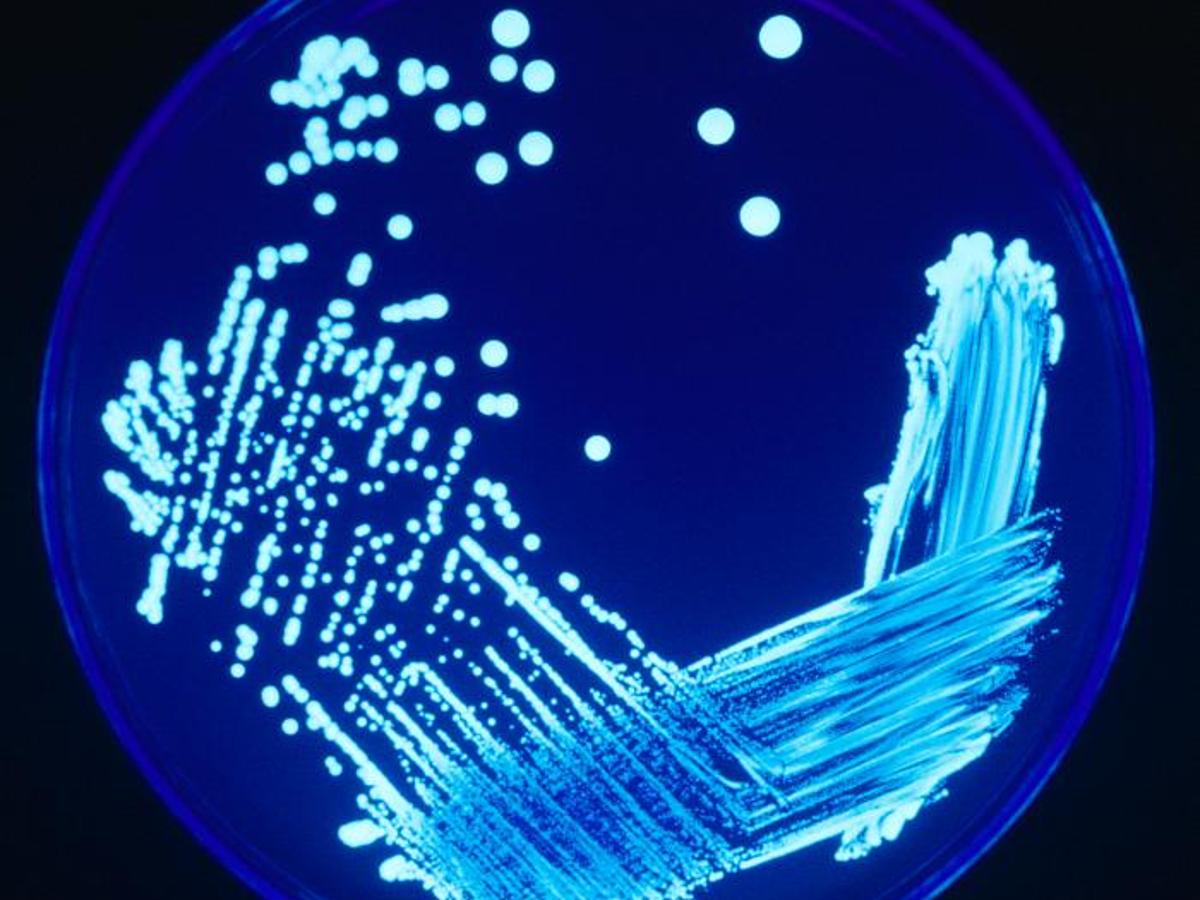

Legionnaires' Disease Wiki
People cant catch Legionnaires disease from person-to-person contact. Since then the number of cases has grown rapidly especially in the last 20 years.
Legionnaires Disease refers to episode 7 of the first season of the television series Forensic Files which was broadcast for the first time on November 7 1996.

Legionnaires' disease wiki. The 1976 Legionnaires disease outbreak occurring in the late summer in Philadelphia Pennsylvania United States was the first occasion in which a cluster of a particular type of pneumonia cases were determined to be caused by the Legionella pneumophila bacteria. Text is available under the Creative Commons Attribution-ShareAlike License. Legionnaires disease is a severe form of pneumonialung inflammation usually caused by infection.
The length of time between exposure to the bacteria and the appearance of. Legionnaires disease is a lung infection you can get from inhaling droplets of water from things like air conditioning or hot tubs. From Simple English Wikipedia the free encyclopedia Legionnaires disease is a form of pneumonia caused by any type of Legionella bacteria.
Legionnaires is a potentially fatal. Legionnaires disease is caused by a bacterium known as Legionella. Additional terms may apply.
Legionellosis that is characterized by severe form of infection producing pneumonia. Its uncommon but it can be very serious. Instead most people get Legionnaires disease.
Legionnaires disease a type of severepneumonia is caused by breathing in small droplets of water that contain Legionella. Infectious disease notifiable disease France 1986 notifiable disease Belgium 1986 notifiable disease Canada 1986. It applies to premises controlled in connection with a trade business or other undertaking where water is stored or used and where there is a means of creating and transmitting breathable water droplets aerosols thus causing a reasonably foreseeable risk of exposure to legionella bacteria.
11 Zeilen This is a list of Legionnaires disease outbreaks. How you get Legionnaires disease You can get Legionnaires disease if you breathe in tiny. In 1976 when 180 Legionnaires contract pneumonia-like symptoms after a convention in Philadelphia Pennsylvania and 29 of them die.
Legion disambiguation This page was last edited on 25 September 2020 at 1153 UTC. Disease on the Rise. Previous outbreaks were retroactively diagnosed as being most probably caused by Legionella bacteria.
Commons Sources of Infection Outbreaks of Legionnaires disease are often associated with large or complex water systems like those found in. Over 90 of cases are caused by Legionella pneumophila. Legionnaires disease contracted by inhaling contaminated water droplets was discovered four decades ago following an outbreak at Philadelphias Bellevue Stratford Hotel during an American Legion convention.

Why Are People Still Dying From Legionnaires Disease News Center University Of Nevada Las Vegas
![]()
Course Path4172017w2 Case 3 Ubc Wiki
Legionella Pneumophila Bacteria Appearance Dangerous Infections And Diseases Legionnaires Disease Legionellosis And Treatment What Causes Legionellosis Organs And Body Parts Affected By Legionella Pneumophila Bacteria Cell Morphology And Gram
Bacterial Diseases Of The Respiratory System Boundless Microbiology

Legionnaire S Disease Info For Nursing Assistant Certifications

File Gorman And Feeley Jpg Wikipedia

Fastidious Gramnegative Bacteria Bacterial Vaginosis Hacek Infections Legionella

Fastidious Gramnegative Bacteria Bacterial Vaginosis Hacek Infections Legionella
Syracuse Hospital Three Patients Contracted Legionnaires Disease One Died Eye On Ny Auburnpub Com

File Ct With Consolidations With Air Bronchograms In Legionnaires Disease Png Wikipedia

Twelve Days Of Waterborne Diseases Salmonellosis Aquamedix

Medi Shower Medishower Twitter

Legionella Micdadei 978 613 7 51558 7 6137515583 9786137515587

File Legionella Pneumophila Sem 2 Jpg Wikipedia
Legionella In Premise Plumbing Systems Qmra

Datei Severe Pneumonia Caused By Legionella Pneumophila Serogroup 11 Italy Jpg Wikipedia

Legionella Pneumophila Causative Agent Of Legionnaire S Disease And Pontiac Fever Facts Pathogenicity Life Cycle Bibliography At Metapathogen

Post a Comment for "Legionnaires' Disease Wiki"